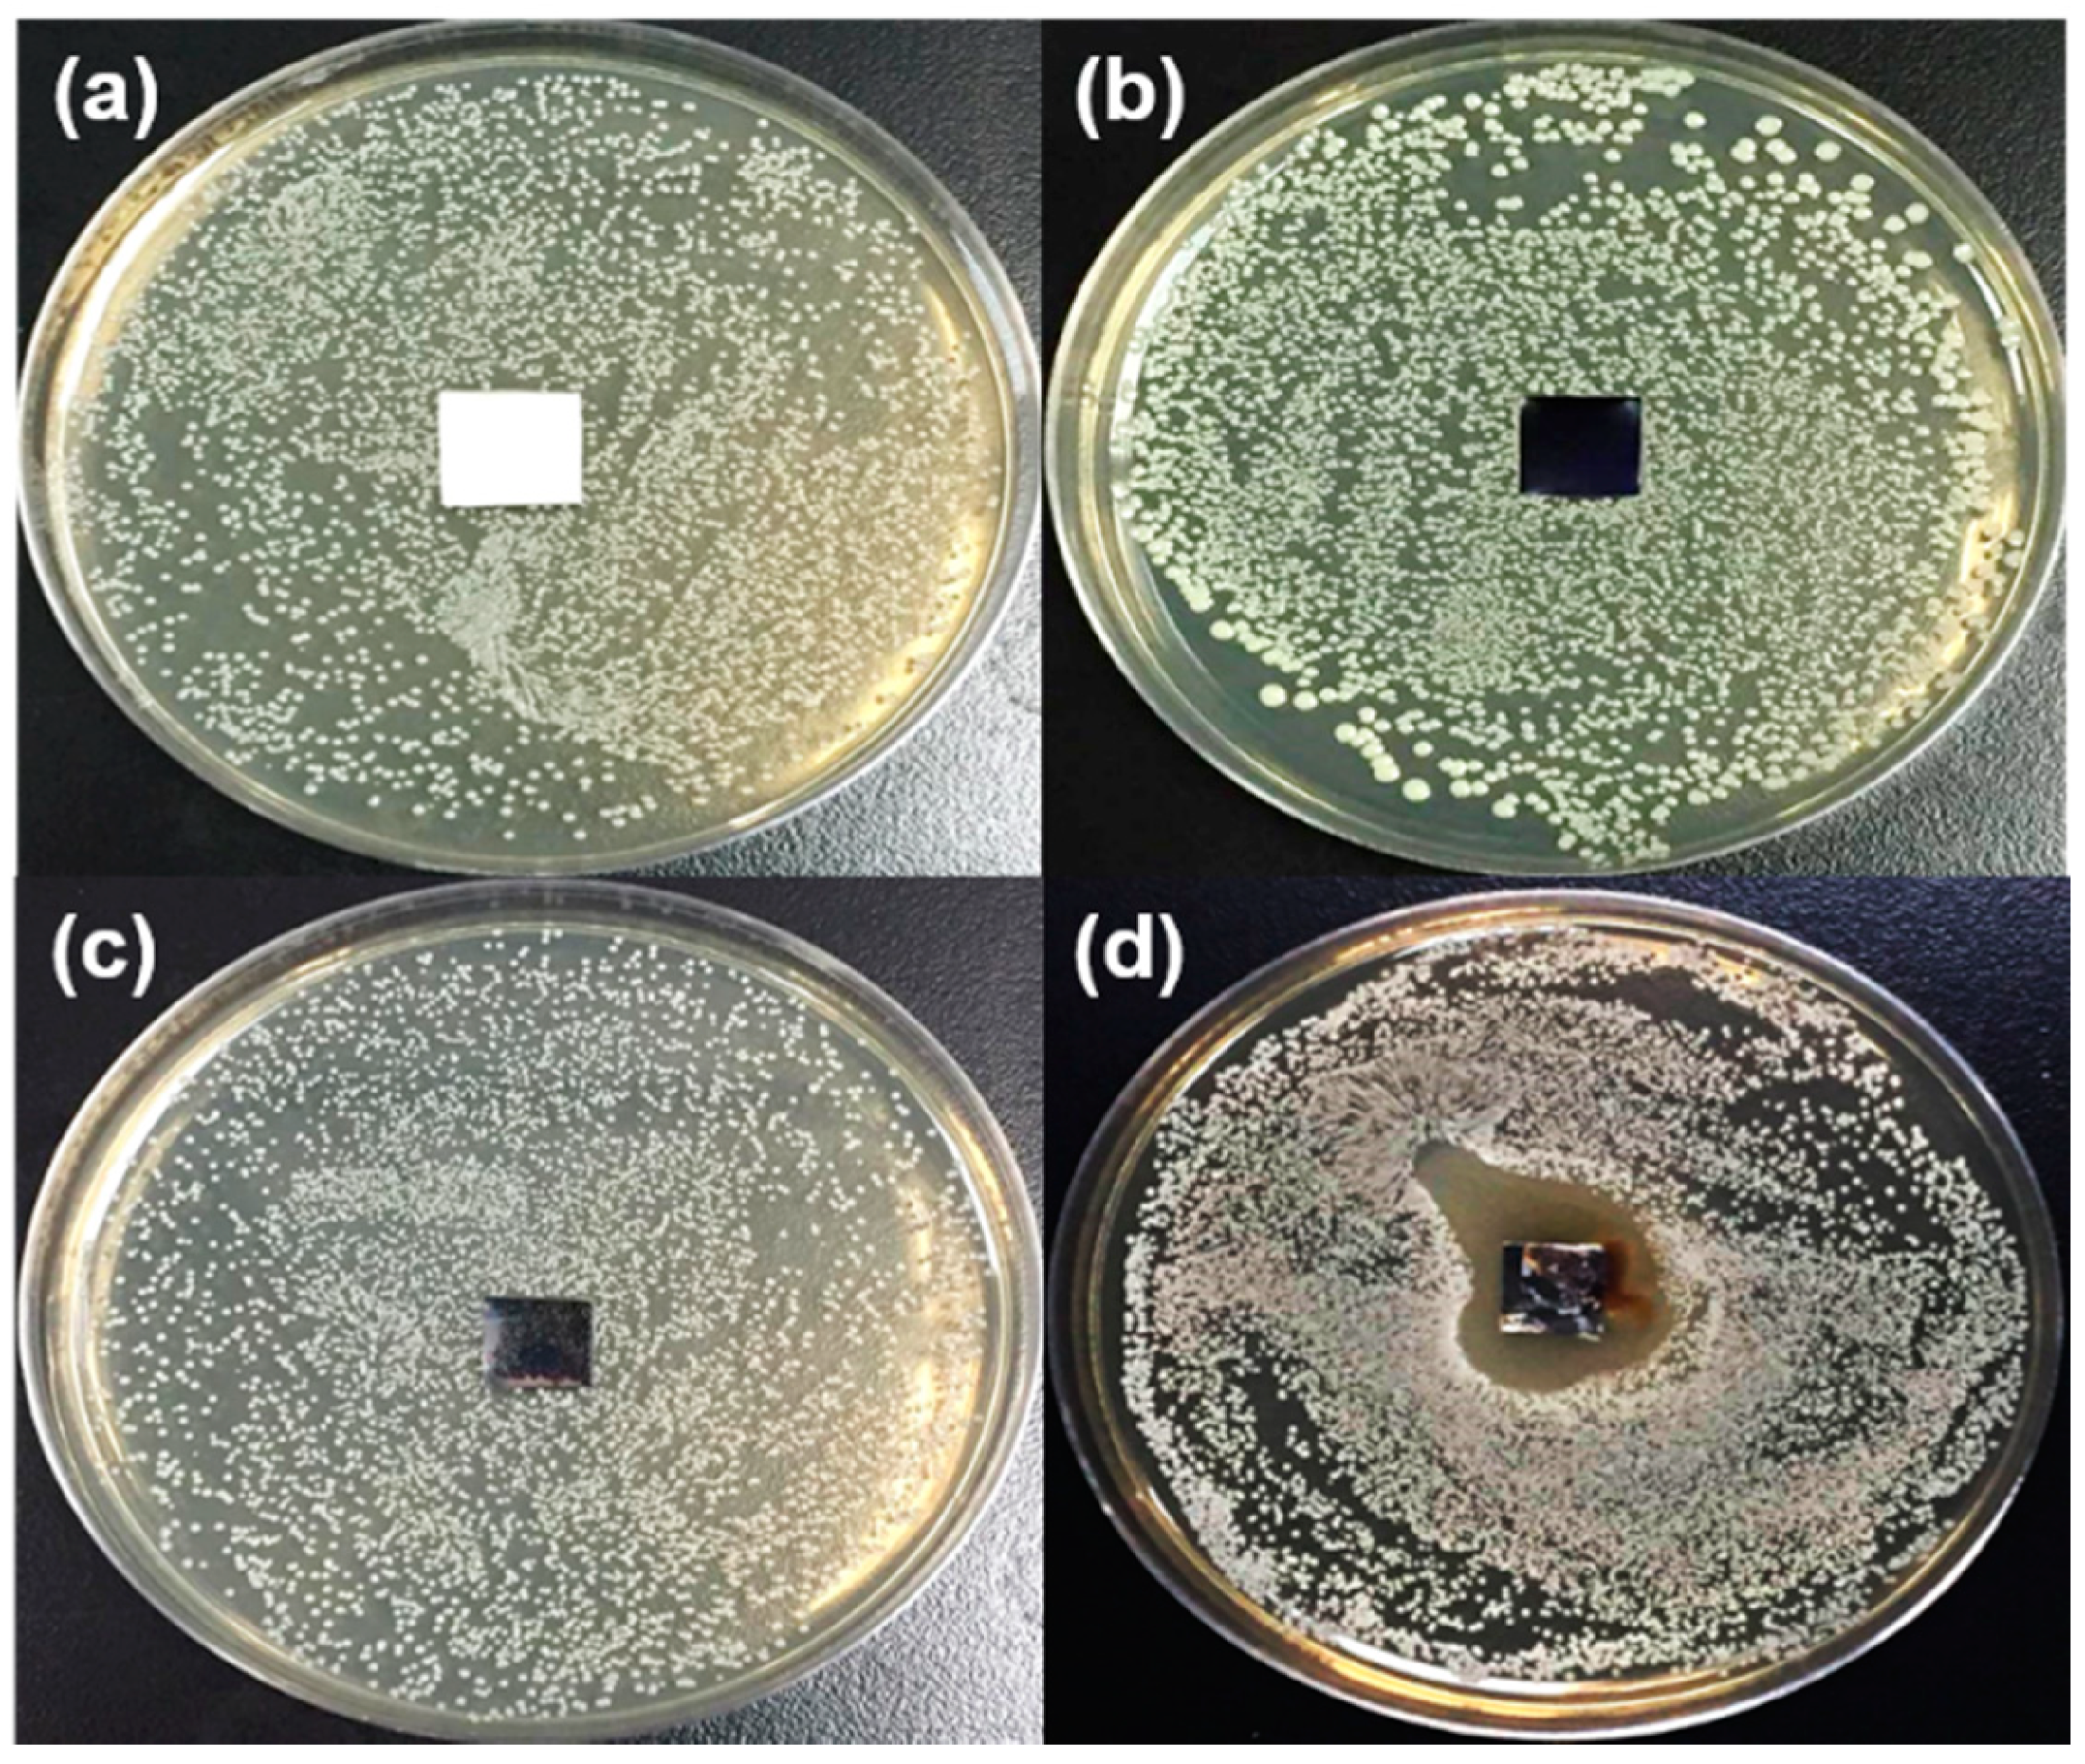
Polymers 12 01467 g009 Polymers 12 01467 g009

Anti-Bacterial and Anti-Fouling Capabilities of Poly(3,4-Ethylenedioxythiophene) Derivative Nanohybrid Coatings on SUS316L Stainless Steel by Electrochemical Polymerization
Abstract
1. Introduction
2. Materials and Methods
2.1. Materials
2.2. Preparation of GO Nanosheets
2.3. Preparation of PEDOT/PSS and PEDOT/GO Nanohybrid Coatings
2.4. Preparation of PEDOT/GO/PDDA Nanohybrid Coating
2.5. Anti-Bacterial Capability of PEDOT Derivatives Nanohybrid Coatings
2.6. Anti-Fouling Capability of PEDOT Derivatives Nanohybrid Coatings
2.7. Characterization
3. Results and Discussion
3.1. Characteristics of PEDOT Derivative Nanohybrid Coatings
3.2. Anti-Fouling Capability of PEDOT Derivative Nanohybrid Coatings
3.3. Anti-Bacterial Capability of PEDOT Derivative Nanohybrid Coatings
4. Conclusions
Author Contributions
Funding
Conflicts of Interest
References
- Zhang, Z.; Tang, J.; Wang, H.; Xia, Q.; Xu, S.; Han, C.C. Controlled Antibiotics Release System through Simple Blended Electrospun Fibers for Sustained Antibacterial Effects. ACS Appl. Mater. Interfaces 2015, 7, 26400–26404. [Google Scholar] [CrossRef]
- Xue, C.-H.; Chen, J.; Yin, W.; Jia, S.-T.; Ma, J.-Z. Superhydrophobic conductive textiles with antibacterial property by coating fibers with silver nanoparticles. Appl. Surf. Sci. 2012, 258, 2468–2472. [Google Scholar] [CrossRef]
- Wu, Q.; Li, J.; Zhang, W.; Qian, H.; She, W.; Pan, H.; Wen, J.; Zhang, X.; Liu, X.; Jiang, X. Antibacterial property, angiogenic and osteogenic activity of Cu-incorporated TiO2 coating. J. Mater. Chem. B 2014, 2, 6738–6748. [Google Scholar] [CrossRef]
- Liu, S.; Ng, A.K.; Xu, R.; Wei, J.; Tan, C.M.; Yang, Y.; Chen, Y. Antibacterial action of dispersed single-walled carbon nanotubes on Escherichia coli and Bacillus subtilis investigated by atomic force microscopy. Nanoscale 2010, 2, 2744–2750. [Google Scholar] [CrossRef]
- Qi, L.; Xu, Z.; Jiang, X.; Hu, C.; Zou, X. Preparation and antibacterial activity of chitosan nanoparticles. Carbohydr. Res. 2004, 339, 2693–2700. [Google Scholar] [CrossRef]
- Cheng, Y.-W.; Wang, S.-H.; Liu, C.-M.; Chien, M.-Y.; Hsu, C.-C.; Liu, T.-Y. Amino-modified graphene oxide nanoplatelets for photo-thermal and anti-bacterial capability. Surf. Coat. Technol. 2020, 385, 125441. [Google Scholar] [CrossRef]
- Adlhart, C.; Verran, J.; Azevedo, N.F.; Olmez, H.; Keinänen-Toivola, M.M.; Gouveia, I.; Melo, L.F.; Crijns, F. Surface modifications for antimicrobial effects in the healthcare setting: A critical overview. J. Hosp. Infect. 2018, 99, 239–249. [Google Scholar] [CrossRef] [PubMed]
- Chen, R.; Sun, K.; Zhang, Q.; Zhou, Y.; Li, M.; Sun, Y.; Wu, Z.; Wu, Y.; Li, X.; Xi, J.; et al. Sequential Solution Polymerization of Poly(3,4-ethylenedioxythiophene) Using V2O5 as Oxidant for Flexible Touch Sensors. iScience 2019, 12, 66–75. [Google Scholar] [CrossRef] [PubMed]
- Kim, J.; You, J.; Kim, E. Flexible Conductive Polymer Patterns from Vapor Polymerizable and Photo-Cross-Linkable EDOT. Macromolecules 2010, 43, 2322–2327. [Google Scholar] [CrossRef]
- Cui, X.; Martin, D.C. Electrochemical deposition and characterization of poly(3,4-ethylenedioxythiophene) on neural microelectrode arrays. Sens. Actuators B Chem. 2003, 89, 92–102. [Google Scholar] [CrossRef]
- Mantione, D.; Del Agua, I.; Sanchez-Sanchez, A.; Mecerreyes, D. Poly (3, 4-ethylenedioxythiophene)(PEDOT) derivatives: Innovative conductive polymers for bioelectronics. Polymers 2017, 9, 354. [Google Scholar] [CrossRef] [PubMed]
- Beesley, D.J.; Price, B.K.; Hunter, S.; Shaffer, M.S.P.; De Mello, J.C. Direct dispersion of SWNTs in highly conductive solvent-enhanced PEDOT:PSS films. Nanocomposites 2016, 2, 135–140. [Google Scholar] [CrossRef]
- Kim, Y.-S.; Chang, M.-H.; Lee, E.-J.; Ihm, D.-W.; Kim, J.-Y. Improved electrical conductivity of PEDOT-based electrode films hybridized with silver nanowires. Synth. Metals 2014, 195, 69–74. [Google Scholar] [CrossRef]
- Horikawa, M.; Fujiki, T.; Shirosaki, T.; Ryu, N.; Sakurai, H.; Nagaoka, S.; Ihara, H. The development of a highly conductive PEDOT system by doping with partially crystalline sulfated cellulose and its electric conductivity. J. Mater. Chem. C 2015, 3, 8881–8887. [Google Scholar] [CrossRef]
- Sun, K.; Zhang, S.; Li, P.; Xia, Y.; Zhang, X.; Du, D.; Isikgor, F.H.; Ouyang, J. Review on application of PEDOTs and PEDOT:PSS in energy conversion and storage devices. J. Mater. Sci. Mater. Electron. 2015, 26, 4438–4462. [Google Scholar] [CrossRef]
- Lövenich, W. PEDOT-properties and applications. Polym. Sci. Ser. C 2014, 56, 135–143. [Google Scholar] [CrossRef]
- Cho, W.; Im, S.; Kim, S.; Kim, S.; Kim, J.H. Synthesis and characterization of PEDOT: P (SS-co-VTMS) with hydrophobic properties and excellent thermal stability. Polymers 2016, 8, 189. [Google Scholar] [CrossRef]
- Novoselov, K.S.; Geim, A.K.; Morozov, S.V.; Jiang, D.; Zhang, Y.; Dubonos, S.V.; Grigorieva, I.V.; Firsov, A.A. Electric Field Effect in Atomically Thin Carbon Films. Science 2004, 306, 666–669. [Google Scholar] [CrossRef]
- Wei, N.; Li, Q.; Cong, S.; Ci, H.; Song, Y.; Yang, Q.; Lu, C.; Li, C.; Zou, G.; Sun, J.; et al. Direct synthesis of flexible graphene glass with macroscopic uniformity enabled by copper-foam-assisted PECVD. J. Mater. Chem. A 2019, 7, 4813–4822. [Google Scholar] [CrossRef]
- Dikin, D.A.; Stankovich, S.; Zimney, E.J.; Piner, R.D.; Dommett, G.H.B.; Evmenenko, G.; Nguyen, S.T.; Ruoff, R.S. Preparation and characterization of graphene oxide paper. Nature 2007, 448, 457–460. [Google Scholar] [CrossRef] [PubMed]
- Lee, J.; Kim, J.; Kim, S.; Min, D.-H. Biosensors based on graphene oxide and its biomedical application. Adv. Drug Deliv. Rev. 2016, 105, 275–287. [Google Scholar] [CrossRef] [PubMed]
- Morimoto, N.; Kubo, T.; Nishina, Y. Tailoring the Oxygen Content of Graphite and Reduced Graphene Oxide for Specific Applications. Sci. Rep. 2016, 6, 21715. [Google Scholar] [CrossRef] [PubMed]
- Yang, D.-Q.; Rochette, J.-F.; Sacher, E. Spectroscopic Evidence for π−π Interaction between Poly(diallyl dimethylammonium) Chloride and Multiwalled Carbon Nanotubes. J. Phys. Chem. B 2005, 109, 4481–4484. [Google Scholar] [CrossRef] [PubMed]
- Yang, M.-C.; Tsou, H.-M.; Hsiao, Y.-S.; Cheng, Y.-W.; Liu, C.-C.; Huang, L.-Y.; Peng, X.-Y.; Liu, T.-Y.; Yung, M.-C.; Hsu, C.-C. Electrochemical Polymerization of PEDOT–Graphene Oxide–Heparin Composite Coating for Anti-Fouling and Anti-Clotting of Cardiovascular Stents. Polymers 2019, 11, 1520. [Google Scholar] [CrossRef] [PubMed]
- Liu, Y.; Weng, B.; Razal, J.M.; Xu, Q.; Zhao, C.; Hou, Y.; Seyedin, S.; Jalili, R.; Wallace, G.G.; Chen, J. High-Performance Flexible All-Solid-State Supercapacitor from Large Free-Standing Graphene-PEDOT/PSS Films. Sci. Rep. 2015, 5, 17045. [Google Scholar] [CrossRef] [PubMed]
- Si, W.; Lei, W.; Zhang, Y.; Xia, M.; Wang, F.; Hao, Q. Electrodeposition of graphene oxide doped poly(3,4-ethylenedioxythiophene) film and its electrochemical sensing of catechol and hydroquinone. Electrochim. Acta 2012, 85, 295–301. [Google Scholar] [CrossRef]
- Sriprachuabwong, C.; Karuwan, C.; Wisitsorrat, A.; Phokharatkul, D.; Lomas, T.; Sritongkham, P.; Tuantranont, A. Inkjet-printed graphene-PEDOT:PSS modified screen printed carbon electrode for biochemical sensing. J. Mater. Chem. 2012, 22, 5478–5485. [Google Scholar] [CrossRef]
- Xu, Y.; Wang, Y.; Liang, J.; Huang, Y.; Ma, Y.; Wan, X.; Chen, Y. A hybrid material of graphene and poly (3,4-ethyldioxythiophene) with high conductivity, flexibility, and transparency. Nano Res. 2009, 2, 343–348. [Google Scholar] [CrossRef]
- Hummers, W.S.; Offeman, R.E. Preparation of Graphitic Oxide. J. Am. Chem. Soc. 1958, 80, 1339. [Google Scholar] [CrossRef]
- Kang, Y.; Chu, Z.; Zhang, D.; Li, G.; Jiang, Z.; Cheng, H.; Li, X. Incorporate boron and nitrogen into graphene to make BCN hybrid nanosheets with enhanced microwave absorbing properties. Carbon 2013, 61, 200–208. [Google Scholar] [CrossRef]
- Österholm, A.; Lindfors, T.; Kauppila, J.; Damlin, P.; Kvarnström, C. Electrochemical incorporation of graphene oxide into conducting polymer films. Electrochim. Acta 2012, 83, 463–470. [Google Scholar] [CrossRef]
- Si, W.; Lei, W.; Han, Z.; Zhang, Y.; Hao, Q.; Xia, M. Electrochemical sensing of acetaminophen based on poly(3,4-ethylenedioxythiophene)/graphene oxide composites. Sens. Actuators B Chem. 2014, 193, 823–829. [Google Scholar] [CrossRef]
- Hsu, C.-C.; Liu, T.-Y.; Peng, X.-Y.; Cheng, Y.-W.; Lin, Y.-R.; Yang, M.-C.; Huang, L.-Y.; Liu, K.-H.; Yung, M.-C. Anti-fouling and anti-coagulation capabilities of PEDOT-biopolymer coating by in-situ electrochemical copolymerization. Surf. Coat. Technol. 2020, 397, 125963. [Google Scholar] [CrossRef]

© 2020 by the authors. Licensee MDPI, Basel, Switzerland. This article is an open access article distributed under the terms and conditions of the Creative Commons Attribution (CC BY) license (http://creativecommons.org/licenses/by/4.0/).
Share and Cite
Hsu, C.-C.; Cheng, Y.-W.; Liu, C.-C.; Peng, X.-Y.; Yung, M.-C.; Liu, T.-Y. Anti-Bacterial and Anti-Fouling Capabilities of Poly(3,4-Ethylenedioxythiophene) Derivative Nanohybrid Coatings on SUS316L Stainless Steel by Electrochemical Polymerization. Polymers 2020, 12, 1467. https://doi.org/10.3390/polym12071467
Hsu C-C, Cheng Y-W, Liu C-C, Peng X-Y, Yung M-C, Liu T-Y. Anti-Bacterial and Anti-Fouling Capabilities of Poly(3,4-Ethylenedioxythiophene) Derivative Nanohybrid Coatings on SUS316L Stainless Steel by Electrochemical Polymerization. Polymers. 2020; 12(7):1467. https://doi.org/10.3390/polym12071467
Chicago/Turabian StyleHsu, Chuan-Chih, Yu-Wei Cheng, Che-Chun Liu, Xin-Yao Peng, Ming-Chi Yung, and Ting-Yu Liu. 2020. "Anti-Bacterial and Anti-Fouling Capabilities of Poly(3,4-Ethylenedioxythiophene) Derivative Nanohybrid Coatings on SUS316L Stainless Steel by Electrochemical Polymerization" Polymers 12, no. 7: 1467. https://doi.org/10.3390/polym12071467
APA StyleHsu, C.-C., Cheng, Y.-W., Liu, C.-C., Peng, X.-Y., Yung, M.-C., & Liu, T.-Y. (2020). Anti-Bacterial and Anti-Fouling Capabilities of Poly(3,4-Ethylenedioxythiophene) Derivative Nanohybrid Coatings on SUS316L Stainless Steel by Electrochemical Polymerization. Polymers, 12(7), 1467. https://doi.org/10.3390/polym12071467
 
        



 
                        